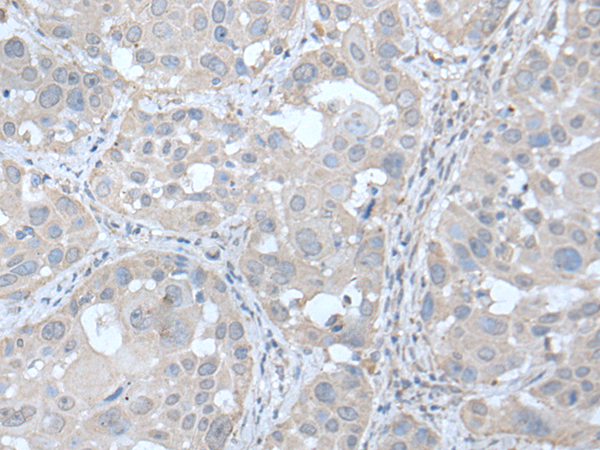

中文名稱: 兔抗UBE2Q2多克隆抗體
|
ackground: |
UBE2Q2 (Ubiquitin-conjugating enzyme E2 Q2) is a 375 amino acid cytoplasmic protein that is involved in ubiquitin-mediated protein degradation. Ubiquitination is an important mechanism through which three classes of enzymes act in concert to target short-lived or abnormal proteins for destruction. The three classes of enzymes involved in ubiquitination are the ubiquitin-activating enzymes (E1s), the ubiquitin-conjugating enzymes (E2s) and the ubiquitin-protein ligases (E3s). One of several members of the ubiquitin-conjugating enzyme family, UBE2Q2 is an E2 ubiquitin-conjugating enzyme that acts to catalyze the covalent attachment of ubiquitin residues to various proteins. UBE2Q2 expression is detected in invasive epithelial tissue and tumor masses including head and neck squamous cell carcinomas, suggesting a role for UBE2Q2 in carcinogenesis. Two isoforms of UBE2Q2 exist due to alternative splicing events. |
|
Applications: |
ELISA, IHC |
|
Name of antibody: |
UBE2Q2 |
|
Immunogen: |
Fusion protein of human UBE2Q2 |
|
Full name: |
ubiquitin conjugating enzyme E2Q family member 2 |
|
SwissProt: |
Q8WVN8 |
|
ELISA Recommended dilution: |
5000-10000 |
|
IHC positive control: |
Human esophagus cancer |
|
IHC Recommend dilution: |
25-100 |
購物車
購物車 幫助
幫助
 021-54845833/15800441009
021-54845833/15800441009
